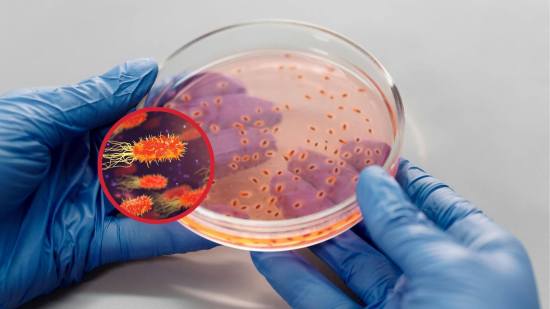
Bacterias que hablan sin palabras ¿cómo usan los microbios la física para comunicarse?

Fundación
La Fundación Muy Interesante nace con el propósito de promover el conocimiento y la divulgación científica en la sociedad. A través de la investigación, la innovación y el fomento del pensamiento crítico, buscamos acercar los avances en ciencia, tecnología, historia y cultura a todos los públicos. Nuestro compromiso es contribuir a una comprensión más profunda del mundo que nos rodea, inspirando curiosidad y ayudando a construir un futuro más informado y sostenible.